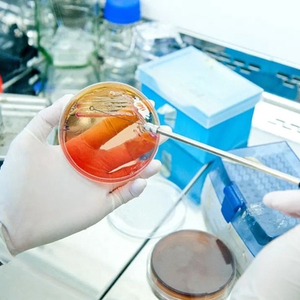

文 | 施露
步入2022年,幽门螺杆菌成为新年A股市场首个热点。主打保健品的交大昂立“蹭”上了这一波热点,1月5日至1月7日三个交易日,因为跻身幽门螺杆菌热门概念,交大昂立连续获得三个涨停。
不过,1月10日,交大昂立早盘开盘封跌停板,而后打开跌停,午后2点20分再度封死跌停板,截至收盘,交大昂立报5.37元/股,跌10.05%。
《证券日报》记者以投资者身份致电交大昂立证券部,截至发稿电话未能接通。
益生菌有辅助作用 幽门螺杆菌防治概念股炒作火爆
幽门螺杆菌防治概念股炒作起源于美国卫生与公众服务部近日发布了第15版致癌物报告,首次将“幽门螺旋杆菌慢性感染”列为人类明确致癌物。
受此影响,幽门螺杆菌防治概念股迎来大涨。多家公司在互动平台表示拥有针对幽门螺杆菌的检测、预防或治疗等相关产品的生产。
对于幽门螺杆菌的治疗方法,1药网首席医学专家刘晓军在接受《证券日报》记者采访时表示,“目前治疗幽门螺杆菌感染的疗法已比较成熟,但幽门螺杆菌的耐药菌株会随着抗生素的广泛应用不断增多,根除治疗的失败率会因此增加,随着抗生素耐药菌株的增多,根除治疗的失败率也会因此增加,目前第一次根治失败率在15%-20%。”
对于益生菌是否可以提高幽门螺杆菌的根除率,刘晓军表示益生菌对提高幽门螺杆菌的根除率有一定的辅助作用,目前根除幽门螺杆菌多采用四联疗法,其中包括两种抗生素,长期使用抗生素会导致胃肠道菌群失调,产生耐药,此时加服益生菌可以调节胃肠道菌群,降低药物的副作用,服用益生菌和抗生素要间隔一定时间,“益生菌”疗法尚未落地。
不过幽门螺杆菌作为新年第一热门概念,一阵风炒作过后一地鸡毛。1月10日,幽门螺杆菌概念股大跌,交大昂立跌停,均瑶健康等多股均出现不同程度下跌。
“幽门螺杆菌防治概念属于细分领域小概念股,属于这个概念的股票不够多,市场资金容量非常有限,如果没有比较多的增量资金参与,这个板块很难形成规模效应,也很难像新能源一样成为二级市场的长期主线。”一位私募研究总监对《证券日报》记者分析。
产品停产不妨碍涨停 背后股东浮盈可观
公开资料显示,交大昂立主营保健品,旗下著名的产品为昂立一号口服液,昂立多邦胶囊、昂立1号益生菌颗粒等,其中昂立一号和昂立多邦曾多次登上电视广告。
1月7日,交大昂立发布公告称,近日,市场提及的与幽门螺杆菌概念有关的我司益生菌产品“昂立超级克幽益生菌粉”已不再生产,敬请投资者注意风险。
神奇的是,在交大昂立宣布旗下幽门螺杆菌产品停产之时,交大昂立当日依旧涨停。
值得注意的是,此番搭上热门概念的交大昂立,虽然旗下相关益生菌概念产品已经停产,但并不阻碍公司股价短期内暴涨,据统计,自2021年12月28日(收盘价计算)至今,交大昂立涨幅近34%。
此外,尤为值得注意的是,在蹭幽门螺杆菌防治概念之前,12月27日,交大昂立控股股东大众交通通过大宗交易方式向一致行动人金澹添利二期基金转让公司股份1550万股,占公司总股本的1.99%,转让均价为3.47元/股。
按照当前的收盘价计算,金澹添利二期基金在接手大众交通的股权后,浮盈54%。
此外,去年12月28日,交大昂立新股东丽水农帮咨询合伙企业(有限合伙),从昂立教育(下称新南洋公司)手中买入交大昂立5.01%的股份,按照转让价3.80元/股,当前丽水农帮浮盈41%。
公开资料显示,交大昂立主营食品及保健食品的原料和终端产品的研发、生产、销售,以及老年医疗护理机构的运营及管理。公司曾因业绩连续亏损于2020年4月30日被实施退市风险警示,沦为“*ST昂立”。而后在2021年5月13日因盈利被撤销退市风险警示。
2021年前三季度,交大昂立共实现营业总收入2.61亿元,同比增长3.80%,实现净利润0.24亿元,同比下降56.46%。